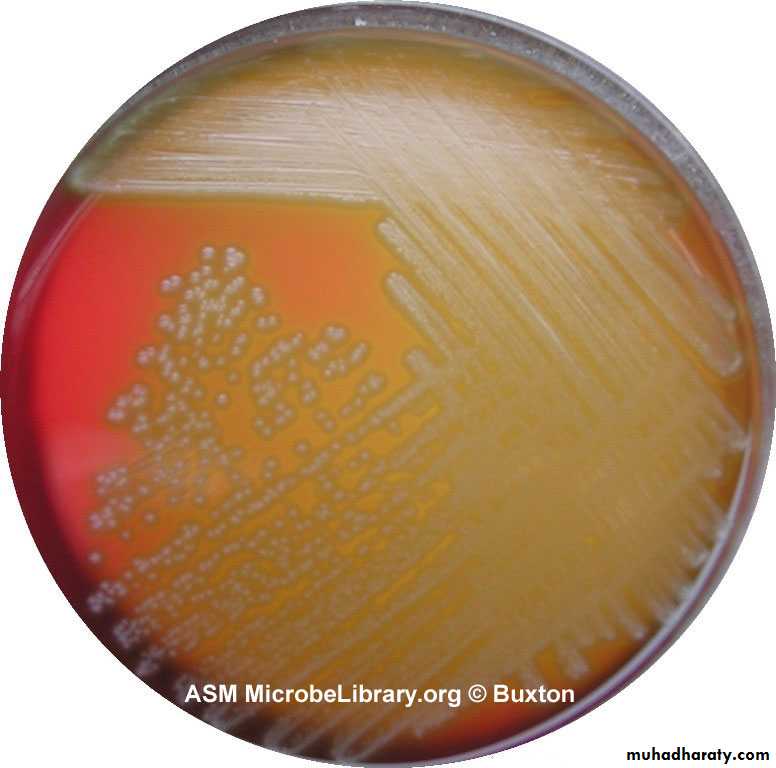
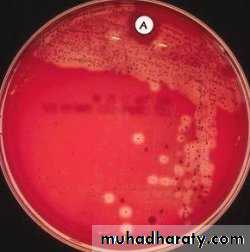
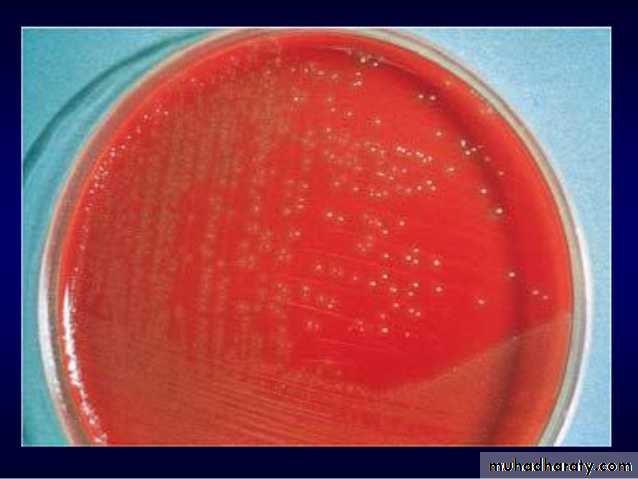

Streptococcus species
Streptococci r G+ve , spherical, that arranged as pairs or chains during growth, some are saprophytic as normal flora of body, others are pathogenic to humans and cause different diseases.Tribe: Actinobacteri
Class: BacilliOrder Lactobacillales
F: Streptococcaceae
Genus : Streptococci
Species : pyogenes, agalactiae, pneumonia ,etc
Streptococcus spp
Streptococcus appears as chain
Streptococci
Stre r heterogeneous group and no one system suffices classify.System use to classification depend on colony growth characteristic, type of hemolysis, antigenic composition of group specific cell-wall substances, biochemical reactions and antigenic composition of the capsular polysaccharide (like Stre. pneumonia)
Classification of strep
Strepto are classified according to oxygen requirements into1- Aerobic: classified into 3 groups
A- alpha – hemolytic Streptococci like S. viridans, and S. pneumoniae
B- beta- hemolytic St as S pyogen
C- Non-hemolytic S. such as S faecalis (enterococcus)
Classification of Stre
2- Anaerobic : it is called Peptostreptococcus which is normaly present in vagina, intestinal tract and upper respiratory tract. It may cause puerperal sepsis, UTI and abscesses.Culture
Poor culture on ordinary media, so it need nutritive requirements like blood and 10% of Co2.Most pathogenic grow best at 37 C˚(especially hemolysis)
Group D (enterococci) grow well at 15 C˚ -45 C˚ and can grow in high Nacl concentration (6.5%).
Most Strep r facultative anaerobic
Antigenic structure
Hemolytic stre can be devided into serologic group (A-H,K-U),certain groups can be subdevided into types, antigenic substances are1-group specific cell w antigen: which is cho, it is lancefield groups(A-H,K-U).
2-M- protein: is a major virulence factor of group A, it’s a hair like projections of streptococcal cell wall, when M protein is present the Stre are virulence
Antigenic structures
3- T-substance:4- R-protein
5-Nucleoprotein
Strep viridans
It is considered as normal flora (commensal) bacteria of the mouth and throat,It can pass the blood especially after teeth extraction or tonsillectomy and this dangerous in people with congenitally deformed or rheumatic heart valves. Organism tend to settle on such areas of abnormal endocardium cause Subacute Bacterial Endocarditis(SBE)
Strepto.vridinas on blood agar
Subacute Bacterial Endocarditis
It is a disease clinically manifested by fever, anaemia, weakness, heart murmur, enlarged spleen and renal lesions.The clinical course is gradual and the disease is fatal in untreated cases
Laboratory Diagnosis
1- blood culture: from febrile attack patient take 5-10 ml of blood and diluted by 50-100 ml of nutrient broth. Incubated at 37 C˚ for at least 24 hrs and then examined byA- subculture on plate of blood agar and examined the colonies, which are surrounded by greenish pigmentation.
B- smear is done from suspected colonies & stained by Grams stain.
Laboratory diagnosis
Stre. Pneumoniae is also give colonies surrounded by greenish pigmentation and it looks like viridans morphologically. Therefore can be differentiate ee them by the followingDifferences St viri Str pneu
Bile solubility insolub soluble
Inuline fer not ferme fermented
Res to optochin res not resistant
Differences
Differences S viridans St pneumoniaPathogenicity no path fatal septicaemi
to mouse
Species of viridans strep
S. mitis, S. mutans, S. salivarius and S. sanguisTreatment of St viridans prolonged course of beta lactam drugs(penicillin and cefalosporin)
Beta haemolytic Streptococci
Streptococcus pyogenes: its important one that causes several medical conditions and found by lancefield that Beta haemolytic strepCan be claasified into many groups from (A-U),
According to cell antigen (specific cho antigen) called C-antigen, the most pathogenic one is group A which is called S pyogen
These above groups subdivided into more than 80 types according to M-protein
Beta hemolytic Streptococci
Beta hemolytic Streptococci
Products of Strep.pyogenes
1- haemolysins: there r two Stroptolysin O, Streptolysin S2-hyaluronidase : spreading factor
3- streptokinase: (fibrinolysin) which tranforms plasminogen into plasmin that digests fibrin into other proteins. It can be used for treatment of coronary artery and venous thrombosis if given I.V.
Products of Strep. pyogenes
4- Erythrogenic toxin: responsible for the characteristic erythema of scarlet fever and it causeses vasodilation of peripheral small blood vesseles.
Diseases caused by group A
Scarlet fever:Way of infection: droplet infection.
Clinical picture: fever, sore-throat, and erythematous skin rash. The disease occurs usually in children.
Diagnosis : 1- schultz-charlton reaction: I.D. injection of antierythrogenic toxin (prepared in animal or from convalescent serum) in one of the erythematous areas will lead to fading and disappearance of the rash within 6-12 hrs in positive cases. This is a neutrilization test in vivo.
Streptococcus pyogenes
2-throt swabs inoculated on b .a. but this not conclusive, because St py. My be present in the throat of normal carriers.Susceptibility to scarlet fever:
This done by the dick test : 0.1 ml of standard erythrogenic toxin is injected I. d. in one forearm (test) and 0.1 ml of heated toxin (inactive) in the other forearm(control)
Results
1- dick positive : erythematous rash in the test forearm and no reaction in the control one this mean susceptible.2- dick negative: no reaction in both forearms this mean immuned.
3- pseudo positive and pseudo negative appear in hypersensitive persons in which reactions appear in both forearms . It may be more sever in the test than the control pseudo positive or more severe in the control than test pseudo negative. Pse + means susceptible , pse –ve means immuned.
Puerperal sepsis
Clinical picture: fever following labour or septic abortion accompanied with foul-smelling uterine discharges.Ways of infection:
1- endogenous : from the patient here -self either from her throat or the commensal anaerobic strep in the vagina.
2- exogenous: from droplets coming from the medical staff or instruments or gloves
Diagnosis
1- A uterine swab is taken and inoculated on blood agar to show the beta haemolytic colonies. Film stained by grams stain.2- Blood culture: the disease always accompanied by bacteremia therefore blood culture is of value
not only st.pyo. Is responsible for puerperal sepsis. Other orgs may be the cause as St.aureus, St epidermidis, E. coli, Stre. faecalis and Closteridium welchii.
Acute follicular tonsillitis
Clinical picture: fever, sore-throat with white spots or membrane on the tonsils. The differential diagnosis may rest between streptococcal infection, diphtheria, vincents angina(combination of spirochaetes and fusiform bacilli) and monilia (fungal infection)Diagnosis of acute follicular tonsillitis
1- throat swab is taken and then inoculated on a plate of b. a.Treatment: broad spectrum antimicrobial agents like beta lactam drugs
Erysipelas
It is a condition characterized by creeping inflammation with vesicular sharply demarcated margin and browny oedema.Way of infection: contamination of wound by Strep. pyogenes.
Diagnosis
The vesicular contents is inoculated on blood agar and examined as before. Blood culture can be used.Treatment of case is penicillin
Impetigo
Clinical picture: it is a local infection of the superficial layers of the skin especially in a small children, leads to the development of superficial blisters which break readily and spread by continuity. The infected area is covered with honey-coloured crustsImpetigo
Diagnosis :
Swabs is taken from the lesion and inoculated on blood agar plate at 37 C˚ for 24 hrsTreatment: beta lactam drugs with local skin ointment
Acute endocartitis
It is associated with streptopccocal infection when occurs bacteremia , beta streptococci may settle on heart valves producing the casePoststreptococcal diseases
Following an acute group A strep infection, there is a latent period of 1-4 wks , after which nephritis or rheumatic fever occasionally . These conditions occur due to hypersensitivity response. Nephritis is commonly preceded by infection of the skin, while the rheumatic fever by infection of the respiratory tract.Acute glomerulonephritis
This is develop after 3wks from strep infect, particularly with m types 2, 4,12, and 49, and some strains are particularly nephritogenic . Glomerulonephritis may be initiate by Ag –Ab complex on the glomerular basement membrane . The Ag is the streptococcal cell membrane. In an acute nephritis there is blood and protein in urine, oedema, high blood pressure and urea nitrogen retention, serum complement levels are lowA few patients die, some develop chronic glomerulonephritis with kidney failure, the majority recover completely.
Rheumatic fever
This is the most serious sequel of haemolytic streptococci infection because it results in damage to heart valves and muscle. Certain strains of group A Stre. Contain cell mem Ag that cross – react with human heart tissue Ags. The onset of rheumatic fever is often preceded by Stre infection 1-4 wks earlier in untreated cases.`
R fever
Typical symptoms of rh f include fever, malaise, migratory polyarthritis and evidence of inflammation of all layers of the heart (endocardium, myocardium, and pericardium) i.e. pancarditis.Diagnosis:
1- Antistreptolysin O titer (ASOT): patients who have had a recent infection , with group A Streptococci develop an antibody response to streptolysin O. this antibody will combine with and neutralize streptolysin O in vitro, thereby inhibiting its haemolytic activity on rbc i.e.Streptolysin O toxin + rbc---- haemolysis.
Streptolysin O toxin+ specific ab at 37 C for 30 min + rbc ----- no haemolysis.
Method
1- serial dilution of patients serum are tested against standard amount of streptolysin O toxin and incubated at 37 C for ½ hr.rabbit Rbcs are added to each tube , and re-incubated for one hr.
The titer is the last tube showing no haemolysis which is expressed as reciprocal of that dilution and the positive case it is usually above 200 units.
Diagnosis
2- C- reactive protein test:CRP is an abnormal alpha globulin that appears rapidly in the serum of patients who have inflammatory condition and is absent in serum from normal person. The test has proved useful in the follow up of patient with rheumatic fever, so CRP disappears when the inflammation subsides, reappearing only when the disease process becomes reactivated.
3- sedimentation rate: it is non –specific because it is high not only in rheumatic fever but also in many other diseases. the test has also proved useful in follow up of the case.
Treatment
1- penicillin as early as possible. Or other beta lactam drugs2- anti-inflammatory drugs, like analgesic and corticosteroid.
3- anticonvulsant medications
4- bed rest
Streptococcus faecalis
Also called enterococcus is always present in colon. If it leaves its normal habitat (the colon), it can cause suppurative lesions, UTI, peritonitis, or puerperal sepsis. It can grow on ordinary media and also on macConkey’s on which it gives deep pink colonies. Enterococcus is quite resistant to many antimicrobial drugs, therefore antibiotic sensitivity test must be done before initiation of treatment.Other Streptococci of medical interest
1- Str agalactia: these are beta haemolytic stre group B they r members of the normal flora of the female genital tract and an important cause of neonatal sepsis and meningitis.2- Peptostreptococcus( many species) these bacteria grow under anaerobic condition or microaerophic con and variable produce haemolysins